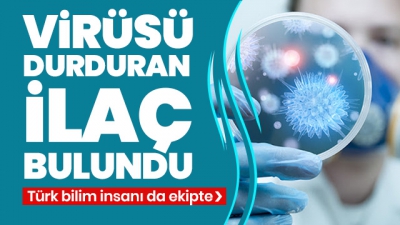
Koronavirüsün bünyeye girmesini engelleyen ilaç bulundu! Türk bilim insanı da ekipte

-
İngiltere'de Kovid-19 paniği: İşler daha da kötüleşecek.Dünya genelinde ise vaka sayısı 723 bini aştı (Corona virüs son durum). Dünya genelini etkileyen yeni tip corona virüs (Covid-19) salgınında hayatını kaybedenlerin sayısı 33 bini, virüs bulaşan kişi sayısı 723 bini geçti, iyileşenlerin sayısı ise 151 b
-
Son dakika: Ulaştırma ve Altyapı Bakanlığı'nda devir teslim töreni! İşte yeni Bakan Adil Karaismailoğlu'nun ilk sözleri.... Son dakika haberi... Ulaştırma ve Altyapı Bakanlığı'nda gerçekleşen devir teslim töreni ile Mehmet Cahit Turhan, görevi yardımcısı Adil Karaismailoğlu'na devretti. Bakan Karaismail
-
Son dakika: Ulaştırma ve Altyapı Bakanlığı'nda devir teslim töreni! İşte yeni Bakan Adil Karaismailoğlu'nun ilk sözleri. Son dakika haberi... Ulaştırma ve Altyapı Bakanlığı'nda gerçekleşen devir teslim töreni ile Mehmet Cahit Turhan, görevi yardımcısı Adil Karaismailoğlu'na devretti. Bakan Karaismail